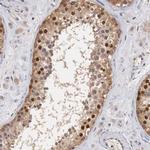
Cyclin B3 Antibody in Immunohistochemistry (IHC)

Search
Invitrogen
Cyclin B3 Polyclonal Antibody
{{$productOrderCtrl.translations['antibody.pdp.commerceCard.promotion.promotions']}}
{{$productOrderCtrl.translations['antibody.pdp.commerceCard.promotion.viewpromo']}}
{{$productOrderCtrl.translations['antibody.pdp.commerceCard.promotion.promocode']}}: {{promo.promoCode}} {{promo.promoTitle}} {{promo.promoDescription}}. {{$productOrderCtrl.translations['antibody.pdp.commerceCard.promotion.learnmore']}}
产品信息
PA5-51391
种属反应
宿主/亚型
分类
类型
抗原
偶联物
形式
浓度
规格
纯化类型
保存液
内含物
保存条件
运输条件
RRID
产品详细信息
Immunogen sequence: KMCASQRKQS CQEESLAVQD VNMEEDSFFM ESMSFKKKPK TEESIPTHKL SSLKKKCTIY GKICHFRKPP VLQTTICGAM SSIKKPTTEK ETLFQELSVL QEKHTTEHEM S
Highest antigen sequence identity to the following orthologs: Mouse - 29%, Rat - 32%.
靶标信息
Cell proliferation is controlled at specific stages of the cell cycle by distinct protein kinase complexes. These complexes consist of a catalytic subunit associating with a specific regulatory subunit to form the active kinase. The cyclins, which include cyclin A, B, C, D, E, F, G, H, I, K, L, T and their related proteins, including Dbf4, comprise the regulatory subunits of these kinase complexes. The controlled activation of the kinase complexes at various intervals of the cell cycle is regulated by the availability of the cyclins to the catalytic subunit. Unlike the catalytic subunit, which is expressed continually, the expression and stability of the regulatory subunit fluctuates depending on the stage of the cell cycle, thereby regulating kinase activity. Cyclin B3, also known as CCNB3 or CYCB3, is a 1,395 amino acid nuclear protein that belongs to the cyclin family of regulatory proteins. Expressed in testis with lower expression in a variety of other tissues, cyclin B3 is thought to be required for early meiotic prophase I, playing an important role in the meiotic cell cycle. Three isoforms of cyclin B3 exist due to alternative splicing events.
仅用于科研。不用于诊断过程。未经明确授权不得转售。
篇参考文献 (0)
生物信息学
蛋白别名: CyclinB3; G2/mitotic-specific cyclin-B3; Protein Ccnb3; unnamed protein product
基因别名: CCNB3; CYCB3
UniProt ID: (Human) Q8WWL7
Entrez Gene ID: (Human) 85417